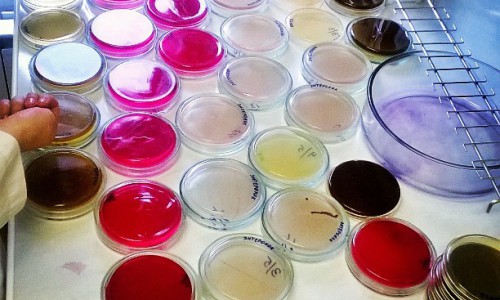
Понедельник в Кирове: разноцветные микробы и иконы в лифте

Автор материалов: Сергей Павленко
Последние новости
Толпа китайцев караулила у бабушкиного огорода и просила продать им сорняк - "чудо", которое в России мало кого интересует
23:30Носки станут белее белого: секрет из советского прошлого, о котором забыли современные хозяйки
23:00Как остановить выпадение волос и отрастить пышную гриву - трихолог раскрыла секрет
22:30С комфортом даже на старой даче: 7 приспособлений, которые сделают загородную жизнь легче
22:00Мороженое из «Красного&Белого», за которым охотятся: стоит ли бежать и покупать — мой честный разбор
21:30О чем молчат, говоря о старости: 5 уроков еврейской мудрости для тех, кому за 70
21:00Никогда не останетесь без денег: 8 мудрых советов из прошлого, которые актуальны сегодня
21:00Оранжевые скорлупки - хит сезона: намазываю этой пастой - получаю пасхальные яйца ярче огненного опала
20:30Соль в унитаз на ночь: утром результат удивил — лайфхак от профессиональной горничной
20:30Почему опытные туристы больше не летят в Анталью: нашли направление с чистым морем и низкими ценами
19:30Почему не нужно спасать тех, кто не просит: мудрые правила жизни от академика Бехтеревой
19:0010-летняя кировчанка стала победительницей шоу "Умнее всех"(6+) с Тиной Канделаки
18:49Жительница Кировской области выступит на передаче у Андрея Малахова
18:34"Агрессивные люди, змеи, грязь и невкусная еда": туристы делятся своим разочарованием от визита в Абхазию
18:30Более 50 тысяч рублей собрали на помощь бойцам СВО: в Мурашинском районе прошла акция "Мы вместе!"
18:12Настоящая весна: известно, какой будет погода в Кирове 29 марта
17:30Почему немцы никогда не чистят грязную обувь, когда приходят домой
17:30Газовые плиты в квартирах с января: новые правила, штрафы и что теперь обязаны сделать владельцы
17:30Первое правило идеальной зажарки для борща: чтобы сварить не свекольные щи, а настоящий борщ - советы от шеф-поваров
16:30Всего 1 кусочек - и ты уже в Турции: рецепт сочных лепешек с картошкой за 15 минут - очень вкусно
15:30Это масло можно брать ящиками: Роскачество назвало лучшие бренды рафинированного подсолнечного масла
15:30Жители Кировской области массово жалуются на дороги и благоустройство
15:15В "Магните" нашли отличный чай для гурманов: стоит пару копеек, а вкус восхитительный
15:00Названы лучшие школы Кирова: кто вошел в топ-10
14:53Теперь прощаемся и с Telegram: названа дата отключения мессенджера
14:30Даже самый дешевый порошок отстирает вещи до идеальной чистоты - вот что сделает стирку в разы эффективней
14:30Привычное лето отменяется: синоптики в панике — такого лета Россия еще не видела
14:00Хотел купить смартфоны - потерял 330 тысяч: кировчанина обманули в Telegram
13:45Добавляю одну ложку в воду и забыла о частой уборке: полы сияют и не пачкаются неделями
13:3012 температурных рекордов побито в Кирове в марте
13:15Ничего не бойтесь: Тамара Глоба предрекла двум знакам зодиака белую полосу в жизни в апреле
13:00Житель Фаленского района с больным сердцем добивался получения необходимых препаратов через президента
13:00"Пшикаю" на садовые дорожки - и "сжигаю" все сорняки: за одни сутки засыхают даже пырей и молочай
12:30В Санкт-Петербурге почтили память С. М. Кирова в день его 140-летия
12:15Длинных майских выходных больше не будет: теперь будем отдыхать по-новому
12:00


В Кирове на Спасской появился новый арт-объект
19 октября 2015
В Кирове ребенок решил сварить для родителей кашу и устроил пожар
19 октября 2015
Понедельник в Кирове: разноцветные микробы и иконы в лифте
19 октября 2015
Спасатели предупреждают о возникновении ЧС в Кирове из-за непогоды
19 октября 2015
Кировчанам предлагают выбрать гимн города
19 октября 2015
В Кировской области грузовик насмерть сбил пешехода
19 октября 2015
Что обсуждают в Кирове: участницу "Битвы экстрасенсов" госпитализировали с сердечным приступом и смертельное ДТП
19 октября 2015
В Кировской области ищут пропавшего 37-летнего мужчину
19 октября 2015
В Кировской области в квартире найден труп бабушки со следами насильственной смерти
16 октября 2015
Житель Кировской области до смерти избил свою мать: подробности происшествия
16 октября 2015
Пятница в Кирове: чистая планета, солнце в городе и школьные дни
16 октября 2015
В Кирове пьяная автоледи протаранила три машины
16 октября 2015
В Кировской области ищут женщину - бомжа: ее подозревают в совершении преступления
16 октября 2015